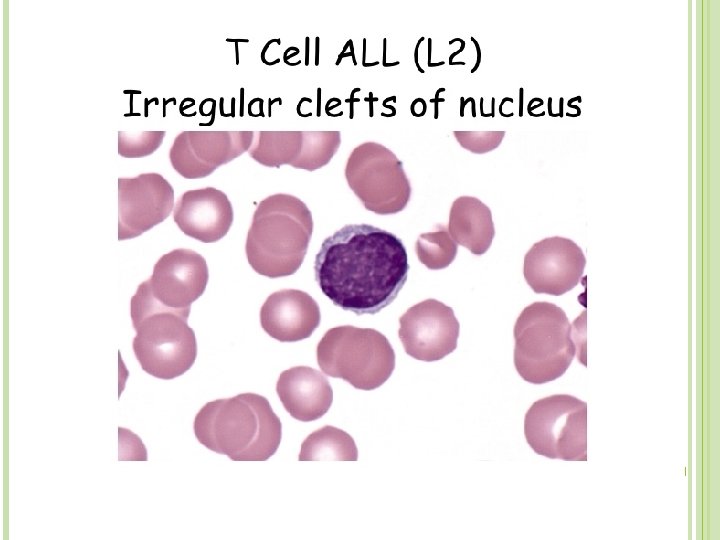
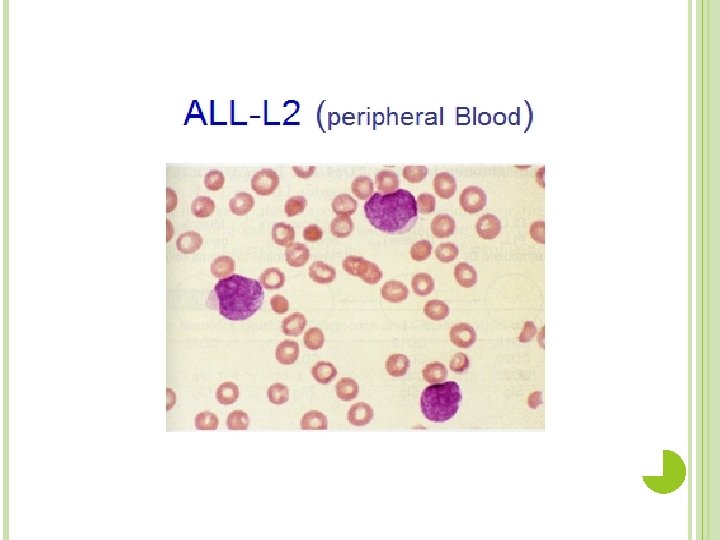

Case study leukemia Noah 6 years old was



































- Slides: 35

Case study leukemia

Noah, 6 years old, was brought back to his pediatrician three weeks following a streptococcal throat infection. His mother was worried that the Strep infection had not cleared up as the child was still complaining of a sore throat and had been very lethargic.

The physician noted that the child looked quite pale. The child's throat was still red, although the pus (a thick whitish-yellow fluid which results from the accumulation of white blood cells, liquefied tissue and cellular debris) and petechiae (tiny red spots in the skin which do not blanch when pressed upon resulting from red blood leaking from capillaries) previously noted with the Strep infection were absent. Ears and chest appeared to be clear although the child cried and seemed to be in pain when the doctor pressed on the sternum. Upon further examination, the physician noted that the child's spleen felt slightly enlarged, as did the lymph nodes. He noted that the child had multiple bruises over his lower extremities. Upon questioning, the mother commented that the child had been experiencing excessive nosebleeds. The physician ordered a CBC, and a throat culture.

Quite pale and red throat (pus) Petachiae spleen felt slightly enlarged Lymph node enlarged Multiple brusises Excessive nosebleed

The results of the laboratory tests were returned the following day. � Preliminary Throat Culture Report. � 3+ endogenous flora. �Note: This report shows that the patient has bacteria normally found in the respiratory tract. No abnormal bacteria such as "Strep" were noted.




After admission to the hospital, Noah was referred to a pediatric oncologist, a doctor who specializes in pediatric diseases of the blood. The oncologist ordered a bone marrow aspirate.

Bone Marrow Smear Results The results of the bone marrow smears showed hypercellularity with sheets of small blasts. These blasts showed a large, regular nucleus and little cytoplasm. There were no visible nucleoli. � Notes: Although blasts are commonly seen in a bone marrow smear, all of the different cell lines should be represented. The preponderance of one cell type suggests a leukemia. The yellow arrow points to a lymphoblast with some cytoplasm present; the red arrow points to a lymphoblast with no visible cytoplasm.

Further testing confirmed the bone marrow results. Noah was L 2 diagnosed with acute lymphocytic leukemia (ALL)

Aspinal tap was ordered to see if the leukemic cells had crossed the blood brain barrier. There were many lymphoblasts in the spinal fluid. In ALL the leukemic cells are often harbored in the meninges

Noah was started on chemotherapy which would kill as many of the cancer cells as possible. He was also given a transfusion of 2 units of packed red blood cells to help alleviate his anemic condition. Noah was released from the hospital but continued chemotherapy treatments weekly. After 3 weeks of chemotherapy treatments, Noah developed a fever of 102°F Examination revealed coarse breath sounds in the right anterior chest. An order was sent to the radiology technician chest radiographs

Chest X _ray result After examining the chest x-rays, the radiologist reported a right, upper lobe infiltrate. Instructor's notes: The infiltrate is the hazy area in the upper right quadrant.

The gram stain report showed 3+ WBC's , and long, thin, gram-negative rods. The culture report showed 4+ Psuedomonas aeruginosa, confirmed the initial gram stain. The physician may start antibiotic therapy based on the initial gram stain Pseudomonas aeruginosa is a common pathogen of immunocompromised patients. It is resistant to many antimicrobials and can be difficult to treat.

Noah was again admitted to the hospital and started on antibiotics to treat a gram negative pneumonia. After 10 days of aggressive antibiotic therapy, another of hest x-rays were ordered.


Noah was now in remission. Two weeks after achieving complete remission, Noah visited a radiology oncologist who al column. Radiation therapy was necessary to insure all leukemic cells harbored in the meninges were eradicated

Noah continued maintenance chemotherapy treatments for two years. A CBC and bone marrow were performed at the wo years

Normocytic Normochromic

Eight years later, Noah is free of any signs of leukemia and is living a normal life.

Acute Leukemia The acute leukaemias are a heterogeneous group of malignant disorders, which are characterized by the uncontrolled clonal proliferation and accumulation of poorly differentiated blast cells in the bone marrow and other tissues.

The signs and symptoms of ALL are variable but follow from bone marrow replacement and/or organ infiltration. • • • Anemia Dizziness Frequent or unexplained fever and infection Weight loss Excessive and unexplained bruising Bone pain, joint pain (caused by the spread of "blast" cells to the surface of the bone or into the joint from the marrow cavity) Breathlessness Enlarged lymph nodes, liver and/or spleen Pitting edema (swelling) in the lower limbs and/or abdomen Petechiae, which are tiny red spots or lines in the skin due to low platelet levels


Risk Factors for Acute Lymphocytic Leukemia? Radiation Exposure Chemical Exposures Inherited syndrome Viral Infections cigarette smoking long exposure to diesel fuel gasoline pesticides electromagnetic fields

Classification of leukemia Main classification Acute leukemia Chronic leukemia FAB Lymphoid Myeloid Lymphoid Myeloid L 1 L 2 L 3 AML M 0 M 1 M 2 M 3 M 4 M 5 M 6 M 7


Cytochemistry

L 2 (ALL) Heterogeneous population of large lymphoblasts with moderately abundant cytoplasm & or more nucleoli. Nucleus commonly intended or cleft. Incidence – ALL is primarily a disease of young children (2 -5 years), but it can also occur in adults Clinical findings – pancytopenia with resulting fatigue, pallor, fever, weight loss, irritability, anorexia, infection, bleeding, and bone pain. L 1 occurs in children, L 2 in adults, and L 3 is called Burkitts leukemia

Thank you Good louk for next group